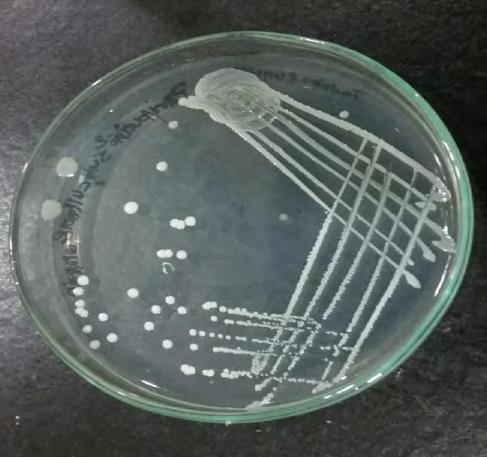
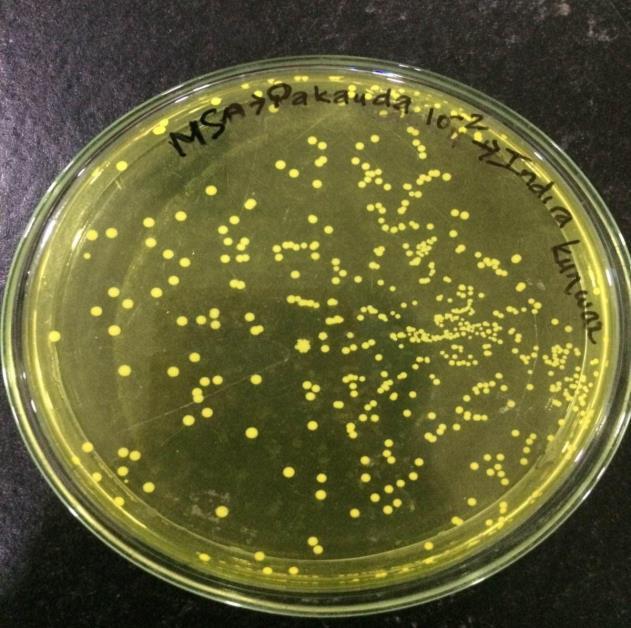

Vol-7, Issue-6; Nov-Dec, 2022
Journal Home Page Available: https://ijeab.com/ Journal DOI: 10.22161/ijeab


Vol-7, Issue-6; Nov-Dec, 2022
Journal Home Page Available: https://ijeab.com/ Journal DOI: 10.22161/ijeab

Department of Microbiology, St.Xavier’s College, Tribhuvan University, Kathmandu, Nepal *Corresponding Author
Received: 25 Nov 2022; Received in revised form: 16 Dec 2022; Accepted: 24 Dec 2022; Available online: 29 Dec 2022 ©2022 The Author(s). Published by Infogain Publication. This is an open access article under the CC BY license (https://creativecommons.org/licenses/by/4.0/).
Abstract A cross-sectional study was conducted on street-vended food randomly from different areas of Kathmandu Valley to assess the number of viable bacteria in street food, distribution of different bacteria, antibiotics resistance profile of isolated bacteria, Methicillin-resistant S aureus (MRSA), and VancomycinResistant S aureus (VRSA) in Kathmandu valley Altogether 339 isolates were identified from one hundred eighty (180) food samples.The average mean plate count ranges from the highest TMTC to the lowest 3.26*108 CFU/ml. In this study, four different spp. of bacteria were identified from different food samples, among them, Escherichia coli (E. coli) was the most frequent isolate 147(43.36%) followed by Staphylococcus aureus (S aureus) 120(35.39%), Salmonella spp. 51(15.04%) and Shigella spp. 21(6.19%). S. aureus was susceptible to penicillin (95%) followed by amoxicillin (75%), ciprofloxacin (60%), and nitrofurantoin (57.5%) E coli was highly susceptible to ciprofloxacin (63.3%) but the Salmonella isolates showed sensitivity towards Amoxicillin which is (76.5%) and Shigella spp. was highly susceptibility towards penicillin (100%) and ciprofloxacin (100%). Distribution of (Multi-Drug Resistant) MDR among total isolates was found to be the highest in Shigella spp. (100%) followed by Salmonella spp (76.4%), S aureus (70%) and E coli (69.38%). Out of 339 isolates, 93 isolates were MRSA and 81 isolates were VRSA, 57 were both MRSA and VRSA. This study showed that the majority of street-vended food items in Kathmandu valley were contaminated with one or more different multi-drug resistant pathogenic bacteria. Therefore, there is a dire need to implement stringent public health measures to mitigate food-borne diseases
Keywords Antibiotic Resistance; MDR; MRSA; VRSA; Street Foods; Sanitation.
Street foods, as defined by Food and Agriculture Organization, are ready-to-eatfoods and beverages prepared and or sold by vendors and hawkers in the streetand public places. Street foods are consumed each day by an estimated 2.5 billion people worldwide (FAO, 2007). Preparation and sale of food onstreet is an old practice in developing countries. Urbanization has augmented the habit of consuming street foods (Tuladhar and Singh, 2012). They are simply eaten as snacks and are an extremely heterogenous food category encompassing drinks, meals, and snacks after being sold from a portable food booth, food
ISSN: 2456-1878 (Int. J. Environ. Agric. Biotech.) https://dx.doi.org/10.22161/ijeab.76.22

cart, or food truck and meant for immediate consumption (FAO, 2007).
In the urban context, the informal sector refers to small enterprise operators selling food and goods or service and thereby involving the cash economy and market transactions to enhance the economy of any country. This so-called “urban informal sector” is more diverse than the rural and includes a vast through which most urban families earn their livelihoods. Street vending is oneof the key manifestations of urban poverty, especially in developing countries like Nepal. Nowit has become agrowing sectorof small-scale economic activity due to the lack of alternative sources of income (Bhowmik, 2005). The use of antibiotics,
the spread of antibiotics, and antibiotic resistance in the clinical setting is a well-recognized problem, but antibiotics and antibiotics resistance as environmental problems and pollutants have largely been overlooked. As a result, the increasing incidence of resistance to a wide range of antibiotics by a variety of organisms is a major concern facing modern medicine (Khan et al., 2020). Hospital wastewater can be hazardous to public health and ecological balance since it can contain many and also pathogenic microorganisms(Saud et al., 2019).
Due to the excessive and inappropriate use of antibiotics, there has been a gradual emergence of a population of antibiotic-resistant bacteria, which pose a global public health problem (Birgen et al., 2020). Uncontrolled use of antibiotics by human and animals results in an increase in antibiotic resistance and cause the spread of resistance genes in environmental samples such as hospital wastewater. Studies have demonstrated that hospital wastewater is a highly selective environment and that they contributeto the highratesofresistant bacteria thatarebeing discharged in the natural environment (Moges et al., 2014). A notorious case is MRSA, which is resistant not only to methicillin but usually also to aminoglycosides, macrolides, tetracycline, and chloramphenicol. Such strains are also resistant to disinfectants, and MRSA canact as a major source of hospital-acquired infections (Nikaido, 2010). MRSA isresistant to entire classes of β-lactams including cephalosporins and carbapenems and has a higher risk of developing of resistance to quinolones, aminoglycosides, and macrolides. However, transferable resistance to vancomycin is now quite common in Enterococcus and founditswayfinallytoMRSAin2002,althoughsuchstrains are still rare. Another serious threat may be the emergence of gram-negative pathogens that are resistant to essentially all of theavailableagents(Sivakumaret al.,2019).Bacterial drug resistance is a worldwide problem that is aggravated by the diminishing numberofnewantimicrobialdrugsinthe pharmaceutical pipeline (Foster 2004).The effectiveness of currently available antibiotics is decreasing due to the increasing number of resistant strains (Khan and Shah, 2015).
Antimicrobialresistant bacteria can be transferred across by human animal and insect vectors. Pests that develop in decaying organic material maytransmit anti-microbial drug resistant bacteria from the manure ofanimals and other decaying organic substrates to residential settings (Chikere et al., 2008). Staphylococcus aureus is an important infectious agent transmitted through various sources including street foods (Lin et al 2018). MRSA is of public health significance; hence the study was taken to assess street foods as a source of MRSA. Large amounts of antibiotics used for human therapy, as well as for farm
ISSN: 2456-1878 (Int. J. Environ. Agric. Biotech.) https://dx.doi.org/10.22161/ijeab.76.22
animals and even for fish in aquaculture, resulted in the selection of pathogenic bacteria resistant to multiple drugs (Adhikariet al.,2017). Multidrug resistance in bacteria may be generated by one of two mechanisms. First, these bacteria may accumulate multiple genes, each coding for resistance to a single drug, within a single cell. This accumulation occurs typically on resistance (R) plasmids. Secondly, multi-drug resistance may also occur by the increased expression of genesthat code for multidrug efflux pumps, extruding a wide range of drugs.
The common foodborne pathogens associated with streetvended foods include Clostridium perfringens, E. coli, Shigella species, Campylobacter jejuni, S aureus, Salmonella species, and Bacillus cereus. The prevalent foodborne diseases are also a result of limited training and poor food safety and handling knowledge among the vendors (Birgen et al., 2020). Antimicrobial resistance (AMR) threatens the effective prevention and treatment of an ever-increasing range of infections caused by bacteria, parasites, viruses, and fungi. It is estimated that each year in the United States there are approximately 76 million foodborne illness cases are caused by Campylobacter species nontyphoidal Salmonella, and pathogenic E coli all colonize the gastrointestinal tracts of a wide range of wild and domestic animals, especially animals raised for human consumption (Hanashiro et al., 2005).
Vendors are often poorly educated, unlicensed, untrained in food hygiene, and they work under crude unsanitary conditions with little or no knowledge about the causes of food-borne disease (Tambekar et al., 2008). In Kenya, approximately 9% of all under-five child deaths are attributable to diarrheal disease. Proper hand hygiene is one of the most effective measures in preventing and controlling the spread of disease. In a recent meta-analysis, hand hygiene was found to reduce diarrheal disease by 31% and respiratory disease by 21% and drying is an important step in the hand-washing process that is often under-emphasized (Mead et al., 2000). E coli is considered a reliable indicator organism of fecal pollution, generally in insanitary conditions of water, food, milk, and other dairy products (Soomro et al., 2002). Cross-transmission of organisms occurs through contaminated hands and using of the same towel. Factors that influence the transfer of microorganisms from surface to surface and affect cross-contamination rates are the type of organism, source and destination surfaces, moisture level, and size of the inoculum (Alanis, 2005).
Food handlers, who harbor antibiotic-resistant bacteria in their gastrointestinal tract may contaminate food which is considered as a potential route MRSA is one of the major human pathogens responsible for mild to serve lifethreatening infections worldwide (Zarefel et al., 2014).
Harrison and colleagues showed that contaminated hands
could contaminate a clean paper towel dispenser and vice versa. The transfer rates ranged from 0.01% to 0.64% and 12.4% to 13.1%, respectively (WHO Guidelines).
The trend of eating street food is increasing gradually in Nepal. Street food previously consisted of Panipuri and Chatpate while at present, we can find all sorts of Chinese and Indian food here (Bhowmik, 2005). Although there are numerous restaurants offering the same things in the spacious and comfortable station. peoplethrougharoundthe smallstalls, mostofthetimestanding duetolack of space, in order to fill their appetite. This happens due to the vast difference in cost for them to get attracted to the stalls (Karkey et al., 2013). The growing population of dwellers in Kathmandu has increased the demandforstreet foods and as such, there has been an increase in the number, and varieties of food sold by vendors. In most places, street foods are sold openly in unhygienic surroundings with houseflies, fruit flies, and dust as the source of contamination.Consumers,ontheotherhand,havenotbeen aware of the serious problems associated with street foods Based on the information and the research carried out, it can be presumed that the street food sample may contain pathogenic organisms and is not safe for consumption. Besides all the problems associated with the qualityof street foods, therehave notbeen much inspection and control over it by the respective administrative sectors. Therefore, this study was conducted to screen various multi-drug resistant bacteria associated with street food sold in the Kathmandu valley and to develop an understanding of the microbiological aspects of disease factors associated with street vended foods.
This study was conducted in the microbiology laboratory at the Department of Microbiology in St. Xavier’s College, Maitighar, Kathmandu.
A cross-sectional study was conducted in street-vended food randomly collected from different areas of Kathmandu Valley to examine the microbiological quality
A total of 180 different types of street food samples were collected, each from Drumstick, Samosa, Aloochop, Panipuri, Mo:Mo, and Pakauda from the crossroad, open shops, bus-station, large street markets, and parks of Kathmandu valley.
This study was conducted from November 2019 to March 2020.
About 15gmof food was collected from each site in a sterile plastic container and sealed. The samples were then carried to the laboratory for further processing
Ten grams(10g) of each food sample were aseptically weighed and mixed with 90 ml of sterile peptone water and homogenized. Serial dilutions were prepared up to 10-10 (Brown, 2007).
From dilution 10-2 to 10-10, 1 ml of diluent was poured in sterile petri plates. About 15ml of molten PCA was added and mixed slowly. The plates were incubated at 37˚C for 24 hours. The colonies were counted and average CFU/ml was calculated (Akter, 2016).
About 0.1 ml homogeneous sample from 10-1 was aseptically transferred onto the surface of sterile mannitol salt agar media plates and sample was spread all over the plates using a sterile bent glass rod. Then plates were incubated for 24 to 36 hours at 37° C and the plates were examined for S aureus which appeared as small circular and smooth with a shiny surface and golden yellow color. The isolated organism was picked up andsubcultured on the nutrient agar medium plate and incubated at 37°C for 24 hours. After obtaining pure culture, the organism was identified on the basis of its morphological characteristics, Gram staining, and biochemical properties (Akter, 2016).
About 0.1 ml from 10-2, 10-4,10-6, 10-8 , and 10-10 dilution was aseptically transferred onto the surface of VRBA plates and spread all over the plates using a sterile bent glass rod. Then plates were incubated for 24-36 hours at 37˚C and the plates were examined for E. coli which appeared as small and pink colonies.
The isolated organism was picked up and subcultured on Nutrient agar mediumplate and incubated at 37˚C for 24 hours. After obtaining pure culture, the organism was identified on the basis of their morphological, cultural and biochemical characteristics.
About 0.1 ml from 10-2 dilution was aseptically transferred onto the surface ofsterile Salmonella- Shigella (SS) agar medium plates, and spread all over the plates using sterile
ISSN: 2456-1878 (Int. J. Environ. Agric. Biotech.) https://dx.doi.org/10.22161/ijeab.76.22
bent glass rod. Then plates were incubated for 24-37˚C and the plates were examined for Salmonella species which appeared. Identification of the isolates was done using Catalase test, Oxidase test, Indole tests, Methyl Red test, Voges Proskauer test, Citrate utilization test, Triple Sugar Iron test, Urease test, Sulphide production test and gas production test.
The isolated organism was picked up and subcultured on nutrient agar medium plate and incubated at 37°C for 24 hours after obtaining pure culture the organism was identified on the basis of their morphological characteristics, Gram staining and biochemical properties.
About 0.1 ml from 10-2 dilution was aseptically transferred onto the surface ofsterile Salmonella- Shigella (SS) agar medium plates, and spread all over the plates using a sterile bent glass rod. Then plates were incubated for 24-37˚C and were examined for Salmonella species which appeared. The isolated organism was picked up and subcultured on nutrient agar medium plate and incubated at 37°C for 24 hours after obtaining pure culture the organism was identified on the basis of their morphological characteristics, Gram staining, and biochemical properties.
Antibiotic sensitivity test by Kirby-Bauer disc diffusion method
Antibiotic sensitivity test was carried out using the KirbyBauer disc diffusionmethod. A sterile inoculating loop was used to pick a colony of the isolate and transferred in each of the 5ml normal saline and homogenized properly until it becomes slightly turbid. Turbidity of the suspension was cross-matched with theturbidity standard (0.5 MacFarland turbidity standards). A sterile cotton swabswas dipped into the bacterial test suspension and was used to evenly inoculate the entire surface of the Muller Hinton Agar Plate (MHA). AntibioticdiscssuchasAmoxicillin, Ciprofloxacin, Nitrofurantoin, Cefoxitin, Vancomycin, Ampicillin, Penicillin, Nalidixic acid, Co-trimoxazole and Chloramphenicol were placed on the surface and press gently using sterile forceps. The plates were incubated inverted for 24 hours at 35˚C. Antibiotic susceptibility was determined after 24 hours by measuring the zone of inhibition in millimeter (Otobo et al.,2018). Isolates which were resistant to 3 or more classes of antibiotics were detected as a Multidrug resistant (MDR) (Magiorakos et al., 2012)
The susceptibility of S aureus isolates to cefoxitin was determined by the modified Kirby-Bauer disc diffusion method following CLSI guidelines. The strains of S aureus which were found to be resistant to Cefoxitin were screened as MRSA.
Detection of VRSA
VRSA was identified using the disc diffusion method. The isolates that were positive cocci, catalase positive, and coagulase-positive were considered S aureus. All the confirmed S. aureus was tested for VRSA using oxide antimicrobial susceptibility vancomycin disc (30 µg/disc) by Kirby Bauer disc diffusion method. Muller Hinton agar (MHA) plates were inoculated with the bacterial suspension which was adjusted to 0.5 McFarland standards (Tiwari et al., 2008).
Sterileforcepswereusedtoplacethevancomycindisc on the agar plates. The plates were incubated at 37˚C for 24 hours. Zone diameter of bacterial growth inhibition surrounding the disc was measured andcompared with CLSI standard which states that vancomycin is sensitive when zone diameter nearest to whole millimeter is ≥15 (Tiwari and Sen, 2006).
Statistical analysis
The data was analyzed by using MS excel.
Quality monitoring of the laboratory equipment, reagent and media
During the project’s experiments, lab incubators, hot air oven, autoclave, etc. were regularly monitored for their performance. The date of expiry of each reagent and biochemical media were checked before preparation and after preparation, each of the media and reagent were labeled properly and stored at suitable condition. Sterility testing of the biochemicalmediawasalso performed at each batch ofthe media prepared.
Hygiene Practices of food vendors during food preparation
Hygiene was observed under the following criteria at Vending site: Personalhygiene ofstreetvendors, Cleanliness of utensils, and the overall environmental conditions nearby vending area as mentioned in the table below.
ISSN: 2456-1878 (Int. J. Environ. Agric. Biotech.) https://dx.doi.org/10.22161/ijeab.76.22
Y=yes, all the time; N=No, not at all
Vendor Hairnets aprons Gloves Store food at the correct temperature
Cover food Clothes clean/ not Utensil clean before use 1.
Total plate count of street food samples.
This study suggests a high total plate count in street foods of Salinadi and Ratnapark which was TMTC followed by
Maitighar (mean coliform count = 6.27 ˟ 108) and Balaju (5.77 ˟ 108) respectively Furthermore, the total plate count in all the samples was high i.e. TMTC except in Pakauda which was 30.21x108 cfu/ml.
Table 1: Total plate count of street food samples.
Location Sample Average Drumstick Samosa Aloochop Panipuri Momo Pakauda
Kalanki 3.7×108 6.71×108 2.7×108 9.53×108 5.7×108 3.86×108 5.36×108 Maitighar 7.13×108 7.94×108 6.41×108 5.42×108 3.7×108 6.90×108 6.27×108 Balaju 5.8×108 6.1×108 6.6×108 5.4×108 6.9×108 6.9×108 5.77×108 Salinadi TMTC TMTC TMTC TMTC TMTC Nil TMTC Ratnapark TMTC TMTC TMTC TMTC TMTC Nil TMTC Newroad 3.82×108 7.1×108 2.8×108 7.6×108 3.7×108 3.7×108 3.97×108 Koteshwor 4.9×108 4.0×108 6.8×108 7.0×108 4.4×108 4.4×108 4.66×108 Subedanagar Nil Nil Nil 9.66×108 Nil Nil 9.66×108
Tinkune 6.0×108 4.0×108 6.8×108 7.0×108 4.4×108 4.4×108 4.83×108 Gongabu 2.5×108 3.9×108 3.4×108 3.1×108 2.8×108 2.8×108 3.26×108
Total TMTC TMTC TMTC TMTC TMTC 30.21x108
A total of 339 bacterial colonies were isolated from 6 different foods collected from 10 different sites in the Kathmandu district. Overall, E. coli was the most
predominantbacteriainstreetfoodsofKathmandufollowed by S aureus, Salmonella species, and Shigella species. Our study also found that all samples of Panipuri were contaminated with E coli
ISSN: 2456-1878 (Int. J. Environ. Agric. Biotech.) https://dx.doi.org/10.22161/ijeab.76.22
N Y Y N Y Y Y
Y Y Y N Y Y Y
N N N N N N Y
N N N N N N Y
N N Y N Y N Y
N Y Y N Y Y Y
N N N N Y Y Y
Y Y Y N Y Y Y
N Y Y N N Y Y
Y N N N Y N Y
Table 2: Growth profile of bacteria according to food sample
Name of foods No. of Sample Bacterial Isolates E. coli S. aureus Salmonella Shigella
Panipuri 30 30 (20.41%) 27 (22.5%) 9 (17.65%) 9 (42.86%)
Aloochop 30 27 (18.37%) 27 (22.5%) 9 (17.65%) 0 Pakauda 30 24 (16.33%) 24 (20%) 6(11.76%) 3 (14.29%)
Drumstick 30 24 (16.33%) 12 (10%) 6 (11.76%) 6 (28.57%)
Mo:Mo 30 18 (12.24%) 9 (7.5%) 12 (23.53%) 3 (14.29%) Samosa 30 24 (16.33%) 21 (17.5%) 3 (5.88%) 0
Total 180 147 120 51 21
Antibiotics susceptibility pattern of the isolated S aureus S aureus showed sensitivity to penicillin (95%) using agar disc diffusion method followed by Amoxycillin, Ciprofloxacin, Nitrofurantoin, Ampicillin, Vancomycin, Cefoxitin with 75%, 60%, 57.5%, 32.5%, and 22.5% respectively.
Table3: Antibiotics susceptibility pattern of S aureus
Antibiotic used S aureus (n= 120) Sensitive Resistant N % N %
Ciprofloxacin 72 60 48 40 Nitrofurantoin 69 57.5 51 42.5 Cefoxitin 27 22.5 93 77.5 Vancomycin 39 32.5 81 67.5 Ampicillin 45 37.5 75 62.5 Amoxycillin 90 75 30 25 Penicillin 114 95 6 5
Antibiotics susceptibility pattern of E. coli
E coli isolates showed highersensitivity towards Ciprofloxacin 93(63.3%), followed byAmoxicillin 81(55.1%) Nitrofurantoin 69(51.0%), Co-trimoxazole 57(38.8%), Cefoxitin 57(38.8%) and Nalidixic acid 45(30.6%).
Table:4 Antibiotics susceptibility patterns of E coli
Antibiotics E. coli (n= 147)
Sensitive Resistant N % N %
Amoxicillin 81 55.1 66 44.9
Ciprofloxacin 93 63.3 54 36.7 Nitrofurantoin 75 51.1 72 48.9 Cefoxitin 57 38.8 90 61.2 Co-trimoxazole 57 38.8 78 53.1 Nalidixic acid 45 30.6 102 69.4
ISSN: 2456-1878 (Int. J. Environ. Agric. Biotech.) https://dx.doi.org/10.22161/ijeab.76.22
Antibiotics susceptibility pattern of Salmonella species
Among the six antibiotics tested against the isolates, Salmonella isolates showed highly sensitivity to Amoxicillin which is 76.5% followed by Nalidixic acid, Cotrimoxazole, Ciprofloxacin, Cefoxitin 70.6%, 52.9%, 47.1%, 5.9% where as 100% resistivity was shown by Nitrofurantoin.
Table 5: Antibiotics susceptibility patterns of Salmonella species.
Antibiotics
Salmonella spp (n= 51) Sensitive Resistant n % N %
Amoxicillin 39 76.5 12 23.5 Ciprofloxacin 24 47.1 27 52.9 Nitrofurantoin 0 0 51 100 Co-trimoxazole 27 52.9 24 47.1 Nalidixic acid 36 70.6 15 29.4 Cefoxitin 3 5.9 48 94.1
Antibiotics susceptibility patterns of Shigella spp.
Among the six antibiotics used for antibiotics susceptibility tests, Shigella isolates show 100% sensitivity to Amoxicillin and Ciprofloxacin whereas 100% resistivity to Nitrofurantoin, Nalidixic acid, Co-trimoxazole, and Chloramphenicol. All Shigella spp. were sensitive to Amoxicillin and Ciprofloxacin.
Table 6: Antibiotics resistivity pattern of Shigella spp.
Antibiotic used Shigella spp. (n= 21) Sensitive Resistant n % N %
Amoxicillin 21 100 0 0 Ciprofloxacin 21 100 0 0 Nitrofurantoin 0 0 21 100 Co-trimoxazole 0 0 21 100 Nalidixic acid 0 0 21 100 Cefoxitin 0 0 21 100
The overall prevalence of MDR (resistance to <2 classes of antimicrobial agents). The higher rate of MDR was observed in Shigella spp. (100%) followed by Salmonella spp (76.4%), Staphylococcus aureus (70%) and Escherichia coli (69.3%).
Table 7: Distribution of multidrug resistance bacteria among bacterial isolates
Bacteria Isolated Multidrug resistant Non multidrug resistant E. coli 102 (69.3%) 45(30.61%) Salmonella spp. 39 (76.5%) 12(23.53%) Shigella spp. 21(100%) 0 S. aureus 84 (70%) 36(30%)
ISSN: 2456-1878 (Int. J. Environ. Agric. Biotech.) https://dx.doi.org/10.22161/ijeab.76.22
Prevalence of MRSA and VRSA among total isolates
Out of total bacteria strain of S aureus, 93(53.5%) were MRSA, 81(46.6%) were VRSA and 57(32.8%) were both MRSA and VRSA
Table 8: Prevalence of MRSA, VRSA, and both MRSA and VRSA
Bacterial isolates Numbers (%)
Methicillin resistance S. aureus (MRSA) 93(53.5%)
Vancomycin resistant S. aureus (VRSA) 81(46.6%) Both MRSA and VRSA 57(32.8%)
Distribution of multidrug resistant bacteria based on types of foods.
Out of 339 bacteria isolated obtained from six street food samples. The MDR were observed in Panipuri sample 51(68%), followed by Drumstick 45(83.3%), Aloochop 42(66.7%), samosa 36(14.6%) and Mo:Mo 30(71.4%).
Table 9: Distribution of multidrug resistant bacteria based on type of foods.
Name of Foods No. of MDR No. of Non-MDR n % n %
Panipuri 51 68 24 32 Aluchop 42 66.7 21 33.3 Pakauda 42 73.7 15 26.3 Drumstick 45 83.3 9 16.7 Mo:Mo 30 71.4 12 28.5 Samosa 36 75 12 25
Distribution of MRSA based on sanitation.
When a relation was statistically determined between growthof MRSA bacteria andpoor sanitation, unhygienic and inadequate sanitary situation, it was found statistically insignificant (p-value 0.7432). There was no association between sanitation condition with growth of MRSA bacteria.
Table 10: Distribution of MRSA based on sanitation Sanitation No. of MRSA No. of non-MRSA P value n % n %
Hygienic 18 75 6 25 0.7432 Unhygienic 75 78.12 21 21.88
Distribution of VRSA based on sanitation
The relation between MDR with hygienic and non-MDR with hygienic condition was also statistically insignificant.
Table11: Distribution of VRSA based on sanitation Sanitation No. of VRSA No. of non-VRSA P value n % n %
Hygienic 15 62.5 9 37.5 0.5594 Unhygienic 66 68.8 30 31.3
Total 81 39
ISSN: 2456-1878 (Int. J. Environ. Agric. Biotech.) https://dx.doi.org/10.22161/ijeab.76.22
Distribution of multidrug-resistant bacteria based on sanitation.

The relation between MDR with the hygienic and non-hygienic conditions was statistically insignificant.
Table12: Distribution of multidrug resistance bacteria based on sanitation
Sanitation No. of MDR No. of non-MDR P value n % n %
Hygienic 45 75 15 25 0.7432 Unhygienic 201 72.04 78 27.9
Total 246 93
ISSN: 2456-1878 (Int. J. Environ. Agric. Biotech.) https://dx.doi.org/10.22161/ijeab.76.22
E. coli, S. aureus, Salmonella, and Shigella are often used as indicator organisms in determining the hygiene level of food handling practices (Walters et al., 2011). At present time, street food vending has become a major community health issue and matter of concern for all of us. A lot of food-borne disease outbreaks are occurring every year worldwide. The reasons behind this include a lack of appropriate knowledge and supervision on street food vending, preparation of food under insanitary conditions, and displaying food openly which also lead to further contamination by dust, insects, rodents, and hands of intending consumers.
ISSN: 2456-1878 (Int. J. Environ. Agric. Biotech.) https://dx.doi.org/10.22161/ijeab.76.22
In this study, altogether 180 street food samples were processed from which 339 isolates were obtained from the samples. When a total count was performed on the PCA agar plate except very few from Mitranagar samples. All other samples are found to contain microorganisms. The study by Raj Bhandari (2014) in Kathmandu reported that all the samples gave a positive PCA count which coincides with the finding of this study. In a study by Mensh et al., (2002), Ghana reported 69.7% positive, out of a total of 511 samples with a positive total count. Another study by Umoh and Odoba (2000) on Nigerian street foods, has reported 26% out of 160 samples with positive growth. In another


study in west India, 100% samples of hamburger patties were found to contain growth (Badrie et al., 2004).
This is an indication that the presence of organisms is common in street foods but that varies with the place and the practice of vendors. When the individual organisms were enumerated in our sample using selective media it was found that E. coli and S. aureus were found in the highest number. They were found to be present in all locations as very few in mitranagar. In each category of the food samples, individual organisms (Salmonella, Shigella, S. aureus, E. coli) were enumerated. During the total plate count, it was found that different food samples contain the different microbial load. Among the enumeration of microbial loads according to different location food, samples of Salinadi and Ratnanagar were found to have the highest number oforganisms i.e. TMTC. Further,thelowest average plate count was found in Gongabu samples i.e. 3.26x108 cfu/ml.
In this study of the distribution of bacteria among different food samples, four bacterial spp. were identified. Among them, E. coli 147(43.4%), S. aureus 120(35.4%), Salmonella 51(15.0%), and Shigella 21(6.2%) etc. were the common isolates S. aureus and E. coli were the major contaminants in the street food samples. Daniels and colleagues (2002) conducted a study in the United States, to describe the epidemiology of food-borne illness outbreaks in schools, colleges, anduniversities. The data from January 1, 1973, to December 31, 1997, was reviewed and found that in majority (60%) of the outbreaks the etiology was unknown. Among the outbreaks with a known etiology, 36% of outbreak reports Salmonella was the most commonly identified pathogen. However, the highest mortality was caused by Listeria monocytogenes. Viral pathogens were responsible for 33% of the outbreaks. Among the viral 41 pathogens, norovirus was the most common causative agent.
In another study by Yadav et al., (2019) in Dhanusha, the highest bacterial sample was S. aureus 38(45.23%) and E. coli 32(38.09%) followed by Salmonella spp. 26(30.95%), Pseudomonas spp. were 18(121.42%). This study also suggests that bacterial contamination is because of the conditions under which it is prepared and vended. In most of the cases running water is not available at vending sites and thus hand and dishwashing is usually done in buckets and sometimes without soaps E. coli spp., Staphylococcus spp., Salmonella spp., Shigella spp. could be due to inadequate hand washing by food workers and the absence of good manufacturing practices crowded areas have a greater number of pathogens than non-crowded areas.
The antibiogram assay of the isolated organism was performed and it was found that S. aureus was found to be
ISSN: 2456-1878 (Int. J. Environ. Agric. Biotech.) https://dx.doi.org/10.22161/ijeab.76.22
sensitive to the following antibiotics: Amoxicillin, ciprofloxacin, Nitrofurantoin, and penicillin while it was resistant to Cefoxitin, vancomycin, ampicillin. Out of the 6 antibiotics tested against E. coli, it was found that it was more susceptible to Amoxicillin, Ciprofloxacin, Nitrofurantoin while resistance to Nalidixic acid, Cotrimoxazole, and Cefoxitin. Similarly, Salmonella was found to be susceptible to Amoxicillin, Nalidixic acid, Cotrimoxazole and was found resistant to Ciprofloxacin, Chloramphenicol, with maximum resistance to 100% to Nitrofurantoin. In a study by Van et al. (2007) in Vietnam the author reported that 50.5% of the Salmonella isolates were found to be resistant to at least one antibiotic, while multidrug resistance was detected in 20.9% of Salmonella isolates and in 61.6% of E. coli isolates. In another study by Watkinson et al, 2007 in Austria, 59% of the E. coli and 25% of Shigella isolates were multidrug resistants. In case of Shigella spp. it was found that Shigella spp. was 100% sensitive to Amoxicillin and Ciprofloxacin while showing 100% resistance to Nitrofurantoin and Nalidixic.
All the samples were subjected to total coliform enumeration over VRBA media and it was found that 147(81.66%) were found to contain E. coli from ten different busy streets where the study was done by Mensah et al (2002). 5.5% of the samples were positive for E. coli and in the study done by Badrie et al (2016). In another report by Bhaskar et al (2004) in Mangalore, out of the 60 food samples, 35% were found to contain E. coli. Similarly, a study done by Van et al (2007) in Vietnam, has reported E. coli was present in more than 90% of all food sources. These data from different places at different times indicate that coliforms, mainly E. coli was one of the common contaminants of street foods. This may indicate that the patterns of street food treatments are similar in those places or that the food is processed with little knowledge of hygiene.
However, it is hard to draw a direct comparison with the results of these studies due to differences in the antibiotics investigated, the level of bacterial contamination and the therapeutic drug practices in the study areas, and the food preparation and preservation practices employed. This study opens a few studies like the efficiency and effects of food preserved that is used by the vendors, the type and quality of water used to prepare the foods, the level of hygienic practices of handling food, and also the prevalence of disease that may have been contributed by consumption of street food.Further, theubiquity ofpathogenicorganisms along with E. coli in street food samples is an indication and question of where our food safety practices stand.
The number of MRSA detected was 93 (53.45%), VRSA was found to be 81(46.55%) where 57(32.76%) were found
to be both. Out of 339 bacterial isolates obtained from six street food sample, the highest MDR were observed in Panipuri sample 51(68%) followed by drumstick, Aloochop, Samosa, and Mo:Mo. The majority of the vendors were found to serve with ungloved hands in our study. The higher amount of organisms in steamed food such as Mo:Mo as detected in this study might be due to the unhygienic nature of utensils used to serve it and the surrounding of the shop. A similar study done by Bantawa et al. (2019), has reported the number of MRSA detected was 93(53.45%), VRSA were found to be 81(46.55%). S. aureus in the food samples might be from direct human interaction, such as skin and diseased cuts or indirectly through tools (Bantawa et al., 2019). When a relation was statistically determined between the growth of MRSA, VRSA, and poor sanitation, unhygienic and inadequate sanitary condition. It was found statistically insignificant with a p-value. There was no association between sanitation conditions with the growth of MRSA and VRSA bacteria. So, MDR and MRSA may be due to contamination of hospital waste material or contaminates in patient care equipment (stethoscope, blood, pressure cuff). So, there should be dedicated medical equipment for a single patient with MRSA Shared equipment should be cleaned and disinfected before using it with another patient and medical wastage should be discarded after proper sterilization.
Resistance to antimicrobial drugs causes increased mortality and morbidity due to infectious diseases. Antibiotic resistance becomes a major worldwide problem. In recent days, these issues are generally considered public health problems and have a significant effect on health. The problem of bacterial resistance to antimicrobial drugs is more troublesome in developing countries like Nepal.
This study was performed in proper lab conditions, however, the exact identification of the isolated organisms by conventional method is not highly reliable and the use of molecular identification technology could have improved the study. This study is neither representative of the whole population of organisms present in the street foods nor or the entire street food consumed in Kathmandu.
This study concludes that the street foods in Kathmandu are readily contaminated with bacteria. Hence, there is a necessity for strict surveillance of the microbial safety of street foods. There should be public involvement projects forpublicawarenessagainst theconsumptionoflow-quality and unhygienic street foods in Kathmandu valley. The findings in this study emphasize the importance of studying multiple genera of bacteria from different foods as sources
ISSN: 2456-1878 (Int. J. Environ. Agric. Biotech.) https://dx.doi.org/10.22161/ijeab.76.22
of human exposure to antibiotic-resistant strains. Most street vendors were illiterate and they did not have clear hygienic knowledge about the preparation, storage, and serving of the food. So street vended ready-to-eat foods should be manufactured under Good Hygienic Practices (GHPs) and preservation practices should be developed in order to minimize the microbial contamination of food. In addition to this, the arising socio-environmental problems are also issues. This study also concludes that the presence of Escherichia coli in a food sample is strong evidence that itis alsocontaminated withotherpotentialpathogens.There is a need to screen other varieties of street food products to screen and identify a variety of organisms other than bacteria that may be a cause of several diseases.
On the basis of the conclusion, the following recommendations are suggested:
• The processing of food should be done with proper hygiene so that contamination can be curtailed.
• Vendors are suggested to use new sterile pair gloves on each preparation and maintain hygiene properly There is also a need for consumer awareness regarding freshness, quality, and hygienic environmental conditions
• Lastly, the concerned Government authorities should periodically check and monitor the preparatory conditionsoftheshops/stallsinordertomaintainthequality of the street foods.
Ms. Pramila Parajuli (Head, Department of Microbiology, St. Xavier’s College)
[1] Adhikari R, Pant ND, Neupane S, Neupane M, Bhattarai R, Bhatta S, Chaudhary R, Lekhak B (2017). Detection of methicillin resistant Staphylococcus aureus and determination of minimum inhibitory concentration of vancomycin for Staphylococcus aureus isolated from pus/wound swab sample of the patients attending a tertiary care hospital in Kathmandu, Nepal. Can J Infect Dis Med Microbiol.
[2] Akter N (2016). Study on bacteriological quality of streetvended foods in Lagos, Nigeria: A potential reservoir for the spread of emerging strains of drug resistant bacteria. Health 5(4):675-680.
[3] Alanis AJ (2005). Resistance to antibiotics: are we in the post-antibiotic’s era? Archives of Medical Research 36(6):697-705
[4] Aneja KR (2007). Experiments in microbiology plant pathology and biotechnology, New Age International 5:1-80
[5] Badrie, N., Joseph, A., & Chen, A. (2004). An observational study of food safety practices by street vendors and
microbiological quality of street-purchased hamburger beef patties in Trinidad, West Indies. Internet Journal of Food Safety, 3, 25-31.
[6] Badrie N, Joseph A and Chen A (2016). An observational study of food safety practices by street vendors and microbiological quality of street-purchased hamburger beef patties in Trinidad, West Indies. Internet Journal of Food Safety 3:25-31.
[7] Bantawa K, Sah S. N Subba Limbu D, Subba P, and Ghimire A (2019). Antibiotic resistance patterns of Staphylococcus aureus, Escherichia coli, Salmonella, Shigella and Vibrio isolated from chicken, pork, buffalo, and goat meat in eastern Nepal. BMCResearch Notes, 12(766):1-6
[8] Bhaskar J, Usman M, Smitha S, and Bhat GK. 2004. Bacteriological profile of street foods in Mangalore. Indian Journal of Medical Microbiology. 22: 97-197.
[9] Bhowmik SK (2005). Street vendors in Asia: a review. Economic and Political Weekly 28:2256-2264
[10] Birgen BJ, Njue LG, Kaindi DM, Ogutu DM and Owade JO (2020). Determinants of microbial contamination of street vended chicken products sold in Nairobi Country, Kenya (18).
[11] Brown A (2007). Benson’s Microbiological Application Laboratory Manual in General Microbiology, Short Version Mc Graw-Hill Higher Education 5:126-129.
[12] ChikereCB,ChikereBOandOmoniVT(2008).Antibiogram of clinical isolates from a hospital in Nigeria. African Journal of Biotechnology 7(24): 4359-4363.
[13] CLSI (2009). Performance of standards for antimicrobial disk susceptibility tests; approved standards M2-A10.
[14] Daniels NA, Mackinnon L, Rowe SM, Bean NH, Griffin PM and MeadPS (2002). ThepediatricinfectiondiseasesJournal, foodborne disease outbreaks in United State school 3(11): 123-131
[15] Food and Agriculture Organization of the United Nation (FAO) (2007). Report on: Improving the nutritional quality of street foods to better meet the nutritional quality of street foods to better meet nutritional quality of street foods to be better meet themicronutrientneed of school children in urban areas, (14-17).
[16] Food and Agriculture Organization of the United Nations (FAO) (2006). The state of food Insecurity in the world 2006.
[17] Foster T.J (2004). The Staphylococcus aureus “superbug”. The Journal of clinical investigation, 114((12): 1693-1696.
[18] Hanashiro A, Morita M, Matte GR, Matte GR, Matte MH, and Torres E (2005). Microbiological quality of selected street foods from a restricted area of Sao Paulo city, Brazil Food control 16:439-444.
[19] Kadariya, J., Smith, T. C., & Thapaliya, D. (2014). Staphylococcus aureus and staphylococcal food-borne disease: an ongoing challenge in public health. BioMed research international, 2014, 827965.
[20] Karkey A, Thompson CN, Thieu NT, Dongol S, Phuong TL, Vinh PV, Arjyal A, Martin LB, Rondini S, Farrar JJ and Dolecek C (2013). Differential epidemiology of Salmonella Typhi and Para typhi A in Kathmandu, Nepal: a matched case-control investigation in a highly endemic enteric fever setting PLOS Neglected Tropical Diseases 7(8):2391-2398.
ISSN: 2456-1878 (Int. J. Environ. Agric. Biotech.) https://dx.doi.org/10.22161/ijeab.76.22
[21] Khan FI and Saha ML (2015). Bacteria-ladenet food (chatpati) and their multiple antibiotic resistance index. Bangladesh J Bot 44(4): 599-604.
[22] Khan SA, Imtiaz MA, Sayeed MA, Shaikal AH and Hassan MM (2020). Antimicrobial resistance pattern in domestic animal-wildlife environmental niche via the food chain to humans with a Bangladesh perspective; a systematic review BMC Veterinary Research 16(302): 1-13.
[23] Lin CY, Wang JH, Link KH, Ho YL and Ho CM (2018). Methicillin-resistant Staphylococcus aureus with reduced susceptibility in Taiwan. Tzu chi Medical Journal 30(3): 135140.
[24] Magiorakos, A. P., Srinivasan, A., Carey, R. B., Carmeli, Y., Falagas, M. E., Giske, C. G., & Monnet, D. L. (2012). Multidrug-resistant, extensively drug-resistant and pandrugresistant bacteria: an international expert proposal for interim standard definitions for acquired resistance. Clinical microbiologyand infection, 18(3), 268-281.
[25] Mansah P, Yeboah-Manu D, Owusu-Darko K and Ablordey A (2002). Street foods in Accra, Ghana: how safe are they? Bulletin of the World Health Organization 80: 546-554.
[26] Moges F, Endris M, Belyhun Y and Worku W (2014). Isolation and characterization of multi-drug resistance bacteria pathogens from waste water in hospital and nonhospital environments, Northwest Ethiopia BMC Research Notes 7(215):1-6.
[27] Nikaido H (2009). Multidrug resistance in bacteria. Annual review of Biochemistry 78: 119-146
[28] Rajbhandari M (2014). Bacterial quality assessment of a popular street food Panipuri of Kathmandu district. Dissertation submitted to Tribhuvan university.
[29] Saud B, Paudel G, Khichaju S, Bajracharya D, Dhungana G, Awasthi MS and Shrestha V (2019). Multidrug-resistant bacteria from raw meat of buffalo and Chicken, Nepal. Veterinary medicine international, 2019.
[30] Sivakumar M, Dubal ZB, Kumar A, Bhilegankar K, Kumar ORV, Kumar Bi, Grace MR, Ramees TP & Dwivedi A (2019). Virulent methicillin resistant Staphylococcus aureus (MRSA) in street vended foods. Journal of Food science and Technology 56(116-1126).
[31] Soomro, A. H., Arain, M. A., Khaskheli, M., & Bhutto, B. (2002). Isolation of Escherichia coli from raw milk and milk products in relation to public health sold under market conditions at Tandojam. Pakistan Journal of Nutrition, 1(3), 151-152.
[32] Tambekar DH, Jaiswal VJ, Dhanorkar DV, Gulhane, PB, and Dudhane MN (2008). Identification of microbiological hazards and safety of ready-to-eat food vended in streets of Amravati City, India. Journal of Applied Biosciences, 7(3): 195-201.
[33] Tiwari HK and Sen MR (2006). Emergence of vancomycin resistant Staphylococcus aureus (VRSA) from a tertiary care hospital from northern part of India. BMC Infectious Diseases 6(156): 1-6.
[34] Tabashsum Z, Khalil I, Nazimuddin MD, Mollah AK, Inatsu Y and Bari ML (2013). Prevalence of foodborne pathogens and spoilage microorganisms and their drug resistant statusin
different street foods of Dhaka city. Agriculture Food & Analytical Bacteriological Journal 3:281-292.
[35] Tiwari HK, Sapkota D and Sen MR (2008). High prevalence of multidrug-resistant MRSA in a tertiary care hospital of Northern India. Infection and Drug Resistance 1:57-61.
[36] Tuladhar Rand Singh A(2012). Bacterial analysisand survey of the street food of Kathmandu in relation to child health. Journal of Natural History Museum 26:1-9.
[37] UmohVJandOdobaMB(1999).Safetyandqualityevalution of street food sold in Zaire, Nigeri. Food Control 10: 9-14.
[38] Van TTH, Moutafis G, Istivan T, Tran LT and Coloe PJ (2007). Detection of Salmonella spp. in retail raw food samples from Vietnam and characterization of their antibiotic resistance. Applied and Environmental Microbiology 73(21):6885-6890.
[39] Waters AE, Contente-Cuomo T, Buchhagen J, Liu CM, Watson L, Pearce K, Foster JT, Bowers J, Driebe EM, Engelthaler DM and Keim PS (2011). Multidrug-resistant Staphylococcus aureus in US meat and Poultry. Clinical Infectious Disease 52(10): 1227-1230.
[40] Watkinson AJ, Micalizzi GB, Bates JB and Costanzo SD (2007). Antibiotic-resistant E. coli in wastewaters, surface waters, and oysters from an urban riverine system. Applied and Environmental Microbiology 73(17): 5667-5670.
[41] Yadav NP and Yadav RK (2019). Bacterial Contamination of street vended food Panipuri available in Janakuradham Dhanusha TUJM 6(1): 70-75.
[42] Zarfel G, GallerH, LuxnerJ, Petternel C, ReinthalerFF, Haas D, Kittinger C, Grisold AD, Pless P, and Feierel G (2014). Multi resistant Bacteria Isolated from chicken meat in Austria. Int J Environ Res Public Health 11: 2582-2593.
ISSN: 2456-1878 (Int. J. Environ. Agric. Biotech.) https://dx.doi.org/10.22161/ijeab.76.22